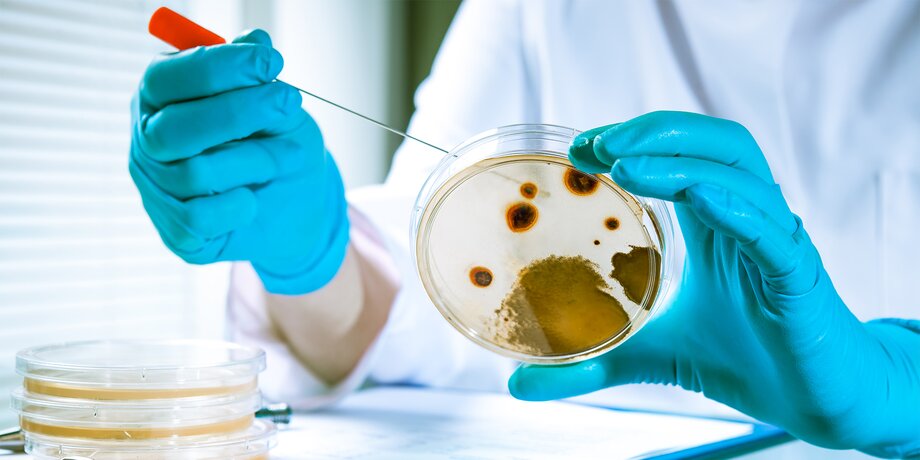

Японские и американские биологи смогли успешно оживить споры древнейших морских микробов. Возраст бактерий составляет около 101,5 миллиона лет. Обозреватель Николай Гринько – о том, к каким последствиям может привести этот неожиданный научный эксперимент.
На сайте научного журнала Nature Communications была опубликована статья о совместных исследованиях японских и американских ученых. Группа исследователей во главе с микробиологом Юки Мороно изучала донные отложения, собранные в районе Южно-Тихоокеанского круговорота. Этот обширный участок (общей площадью 37 миллионов квадратных километров) считается практически безжизненным с точки зрения морской биологии.
Причина в том, что эта территория ограничена системой замкнутых течений, крайне неохотно взаимодействующих с окружающими водными массами из-за разницы температур и давления. Кроме того, круговорот расположен на большом расстоянии от материков (кстати, из-за этого его используют как "космическое кладбище" – именно туда падают отработанные спутники).
Ученым же этот участок океана интересен прежде всего тем, что донные отложения накапливаются здесь очень медленно – примерно на полтора метра за миллион лет, а значит, добыть древние геологические образцы относительно просто.
Еще в 2010 году исследователи опустили глубоководный бур к самом дну (под шестикилометровую толщу воды), а затем пробурили отложения приблизительно на сотню метров. Таким образом, в их распоряжении оказались образцы породы возрастом от 4,3 до 101,5 миллиона лет. И лишь совсем недавно биологи решили исследовать их на предмет наличия следов ископаемой жизни. Каково же было их удивление, когда в толще обнаружились бактерии, причем живые! Если точнее, они находились в глубочайшей спячке – их жизненные процессы протекали невероятно медленно. Но все-таки протекали!
Интересно, что подавляющее большинство найденных бактерий были аэробными – то есть для жизнедеятельности им требуется кислород. Откуда же взялся кислород в толще океанского дна? Все дело в том, что в этом районе океана практически нет сколько-нибудь крупных форм жизни: в результате мертвая органика не накапливается на дне и не мешает кислороду из морской воды медленно проникать в дно.
Ученые смогли найти в образцах донных пород 6 986 отдельных клеток. Поместив их в питательную среду и дав доступ к кислороду (его было примерно в шесть раз меньше, чем в атмосфере), биологи обнаружили, что бактерии начали питаться и даже размножаться – пробудились почти все, приблизительно 99,1%.
Эксперимент длился 68 дней, и за это время количество клеток увеличилось на 4 порядка, то есть в 10 000 раз. Группа ученых завершает свой отчет выводом о том, что аэробные бактерии могут сохранять жизнедеятельность при минимальном количестве кислорода и питательных веществ как минимум в течение 101,5 миллиона лет.
Понятное дело, общественность, ознакомившись с публикацией, заволновалась: не смогут ли древние бактерии, пролежавшие в толще пород сто с лишним миллионов лет, нанести вред современной экологии или даже стать возбудителями каких-нибудь болезней? Но ученые уверяют, что полностью контролируют размножение биоматериала, да и об опасности, которую он мог бы представлять, исследователям ничего не известно.
Скептики же обратили внимание на осторожные формулировки отчета: в нем не сказано, что найденные бактерии были того же возраста, что и окружающие их отложения, говорится лишь, что они "извлечены из породы возрастом приблизительно 101,5 миллиона лет". Может быть, они оказались внутри намного позже? Где гарантия, что бактерии не попали в образцы уже после извлечения с океанского дна, ведь их целых десять лет хранили в лаборатории?
Все эти соображения, конечно, немного успокаивают. Хотя…








Сергей Собянин поздравил коллектив СВАРЗ с 120-летием завода
Гринько Николай



























